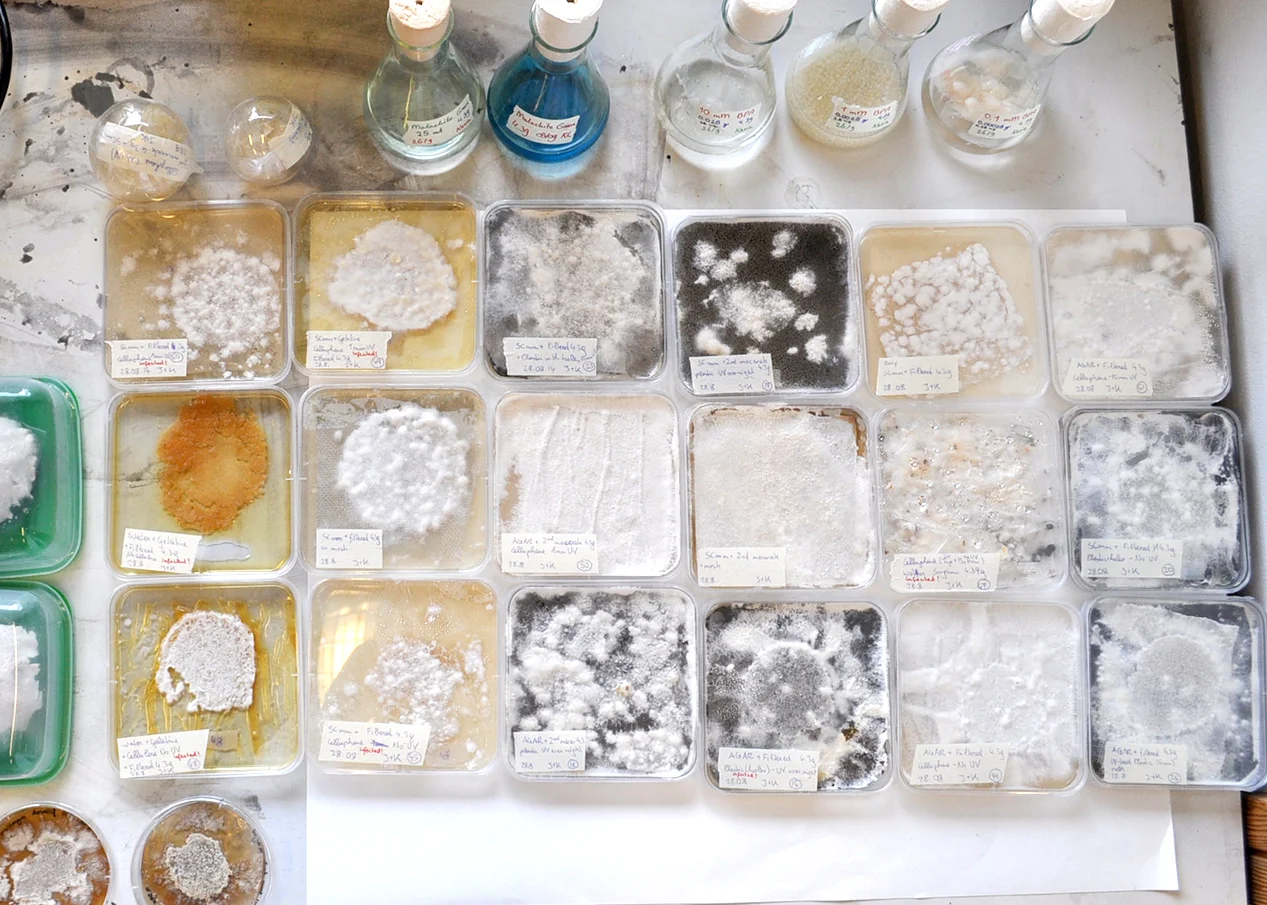
Elaborate experiments in the Utrecht University Lab

FUNGI MUTARIUM
Growing Food on Toxic Waste
Livin Studio has, in collaboration with Utrecht University, developed a novel fungi food product grown on (plastic) waste, a prototype to grow it and culinary tools to eat it. Please go to FUNGI CUTLERY to explore our culinary tools developed throughout this project.
Fungi Mutarium is a prototype that grows edible fungal biomass, mainly the mycelium, as a novel food product. Fungi is cultivated on specifically designed agar shapes that the designers called "FU". Agar is a seaweed based gelatin substitute and acts, mixed with starch and sugar, as a nutrient base for the fungi. The "FUs" are filled with plastics. The fungi is then inserted, it digests the plastic and overgrows the whole substrate. The shape of the "FU" is designed so that it holds the plastic and to offer the fungi a lot of surface to grow on.
Its shape has been developed inspired by mushrooms and other plants in nature. The user should be reminded of harvesting mushrooms in the wild when harvesting the "FUs".
Schemata of agar "FUs"
Agar "FU" experiments in the laboratory
"FU´ppetite" !
FUNCTION:
1) Plastic is UV treated in the "Activation Cylinder" placed on the bottom of the mutarium. UV light sterilizes the plastic and activates the degradation process of the plastic which makes it easier accessible for the fungi.
2) Plain „FU“ is placed in the mutarium´s Growth Sphere. This is done with pincers to work as sterile as possible.
3) UV-sterilized plastic is put into the „FU“, ready to be digested.
4)„Macerate“ (fungi sprouts in liquid nutrient solution) are extracted with a pipette from the Fungi Nursery.
5) Extracted macerate is dropped into the „FUs“ to ignite the growing process.
6) After a couple of weeks, the ready-grown „FU“ can be taken out to be prepared and eaten.
WHY:
Food production has to be revolutionized and more technologies are needed to farm under extreme environmental conditions.
HOW:
Scientific research has shown that fungi can degrade toxic and persistent waste materials such as plastics, converting them into edible fungal biomass. We were working with fungi named Schizophyllum Commune and Pleurotus Ostreatus. They are found throughout the world and can be seen on a wide range of timbers and many other plant-based substrates virtually anywhere in Europe, Asia, Africa, the Americas and Australia. Next to the property of digesting toxic waste materials, they are also commonly eaten.
As the fungi break down the plastic ingredients and don´t store them, like they do with metals, they are edible.
Geographical Zones of Growth and Culinary Interest
Elaborate experiments in the Utrecht University Lab
Process Sketch Modeling: Most of the design work was dealing with functionality of separation of fungal mass, plastics and substrate
Fungi Mutarium is a conceptual device that presents ongoing research and is currently not a commercially available product.
This project was funded by the Bio Art and Design Award and generously supported by Utrecht University.
The Bio Art and Design Award is a collaboration between NWO (Dutch Research Council- Earth and Life Science, Humanities, The Hague), ZonMW (Medical Research Council, The Hague), MU Artspace (Eindhoven) and Waag Society (Amsterdam).
credits of project: Katharina Unger and Julia Kaisinger for LIVIN Studio
research partner: Utrecht University, Prof. Dr. Han Wösten, Kasia Lukasiewiecz